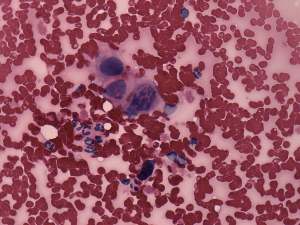

Thyroid cancers - case 1467 |
|
Clinical data: A 60-year-old woman was referred for an evaluation of a rapidly increasing tumor which evolved over 6 weeks.
Palpation: a very hard, fixed tumor in the right lobe and in the isthmic part of the thyroid.
Functional state: euthyroidism (TSH 0.96 mIU/L, FT4 16.6 pM/L).
Ultrasonography revealed a hypoechogenic mass in the right lobe and in the isthmus with small cystic areas. The nodule was avascular on Doppler mode.
Cytological diagnosis: anaplastic carcinoma.
Histopathology: anaplastic cancer.
.